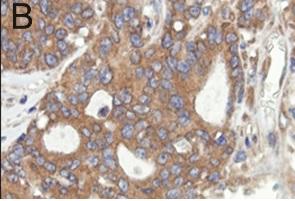
CANCER: Couper les vivres aux cellules tumorales via leurs capteurs alimentaires – Oncogene CANCER: Couper les vivres aux cellules tumorales via leurs capteurs alimentaires – Oncogene

Les tumeurs ont recours à des protéines spécifiques pour détecter les sources alimentaires nécessaires à leur croissance. Ce nouvel axe de recherche, poursuivi par une équipe de l’Université d’Oxford, consiste à leur » couper les vivres « . Il s’agit d’identifier les capteurs » alimentaires » des cellules cancéreuses et à les inhiber pour bloquer l’accès des cellules aux nutriments essentiels à leur développement. Une nouvelle étape présentée dans la revue Oncogene, sur une voie prometteuse qui a déjà fait l’objet de précédents travaux.
Les tumeurs ont recours à des protéines spécifiques pour détecter les sources alimentaires nécessaires à leur croissance. Ce nouvel axe de recherche, poursuivi par une équipe de l’Université d’Oxford, consiste à leur » couper les vivres « . Il s’agit d’identifier les capteurs » alimentaires » des cellules cancéreuses et à les inhiber pour bloquer l’accès des cellules aux nutriments essentiels à leur développement. Une nouvelle étape présentée dans la revue Oncogene, sur une voie prometteuse qui a déjà fait l’objet de précédents travaux.
Priver les cellules cancéreuses de nutriments, peut s’effectuer de plusieurs manières. Bloquer l’angiogenèse, déjà reconnue comme un facteur majeur de croissance du cancer, car la formation de nouveaux vaisseaux sanguins est nécessaire pour apporter de l’oxygène et des nutriments aux cellules cancéreuses. S’attaquer directement aux protéines qui permettent l’approvisionnement des cellules
L’équipe de l’Université d’Oxford identifie ici une protéine utilisée par les tumeurs pour les aider à détecter les approvisionnements alimentaires. Cette protéine, appelée PAT4, fabriquée par les cellules cancéreuses agressives et donc retrouvée à niveaux plus élevés en cas de cancer permet aux cellules cancéreuses de s’approprier en quelque sorte les nutriments disponibles au dépend des cellules saines. Cette protéine semble donc conférer, aux cellules cancéreuses, une capacité particulière à détecter et acquérir les nutriments essentiels à leur survie et leur développement.
Une protéine clairement associée au développement tumoral : L’idée était donc ici de développer ou trouver un anticorps qui pourrait être utilisé pour mettre en évidence PAT4 (en marron sur visuel B) dans des échantillons de tissus humains. Cet anticorps une fois trouvé par l’équipe, a été utilisé pour l’étude d’échantillons de tumeurs prélevés chez des patients atteints de cancer colorectal. Les résultats ont ensuite été comparés aux résultats de santé déjà connus des patients : Des niveaux plus élevés de PAT4 dans les tumeurs s’avèrent bien associés à de mauvais résultats de santé et à un pronostic moins favorable.
Et lorsque les niveaux de PAT4 sont réduits ? Alors, les tumeurs cancéreuses progressent plus lentement. Pouvoir réduire les niveaux de cette protéine » capteur » de nutriments permet d’améliorer le pronostic. C’est donc ici un mécanisme cible qui vient d’être identifié et apparaît prometteur dans le cadre d’un traitement combiné.
Source: Oncogene 5 October 2015 doi: 10.1038/onc.2015.363 PAT4 levels control amino-acid sensitivity of rapamycin-resistant mTORC1 from the Golgi and affect clinical outcome in colorectal cancer (Visuel@ Oxford University)


